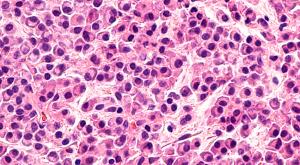
image of myeloma represented with colors of pink and purple.

Among patients in the real world with unresectable or metastatic urothelial carcinoma, Padcev significantly improved overall survival outcomes.

Among patients in the real world with unresectable or metastatic urothelial carcinoma, Padcev significantly improved overall survival outcomes.

No significant survival benefits were found when comparing three CDK4/6 inhibitor combinations during initial treatment for HR-positive, HER2-negative metastatic breast cancer.

Patients with relapsed or refractory (R/R) myelofibrosis experienced reduced biomarkers of disease severity following treatment with navtemadlin.

In patients with unresectable liver cancer, treatment with Imjudo plus Imfinzi showed better survival outcomes compared with Nexavar.

First-time treatment with Lenvima continues to outperform other treatments for thyroid cancer.

For patients with cisplatin-ineligible bladder cancer, presurgical Padcev decreased the cancer stage without leading to delays in surgery.

Jakafi plus Rezurock showed promise in treating graft-versus-host disease in patients who underwent undergone allogeneic hematopoietic cell transplantation.

Most patients with relapsed or refractory multiple myeloma responded to treatment with the CAR-T cell therapy, Carvykti, according to a small study.

Real-world data demonstrated that knowing a patient’s stage and subtype of renal cell carcinoma, a type of kidney cancer, may provide cancer teams with the information needed to determine potential prognosis and recurrence risk.

Research is underway on the immune-stimulating antibody conjugate BDC-1001’s effectiveness against HER2-positive cancers when combined with Perjeta, according to data presented at SABCS.

A treatment combination that includes Velcade and Rituxan helps improve responses and the safety profile in marginal zone lymphoma, according to a phase 2 trial.

Patients with multiple myeloma who are undergoing systemic treatment can see improvements from exercise, a recent study shows.

Published: February 24th 2024 | Updated:
Published: February 23rd 2024 | Updated: